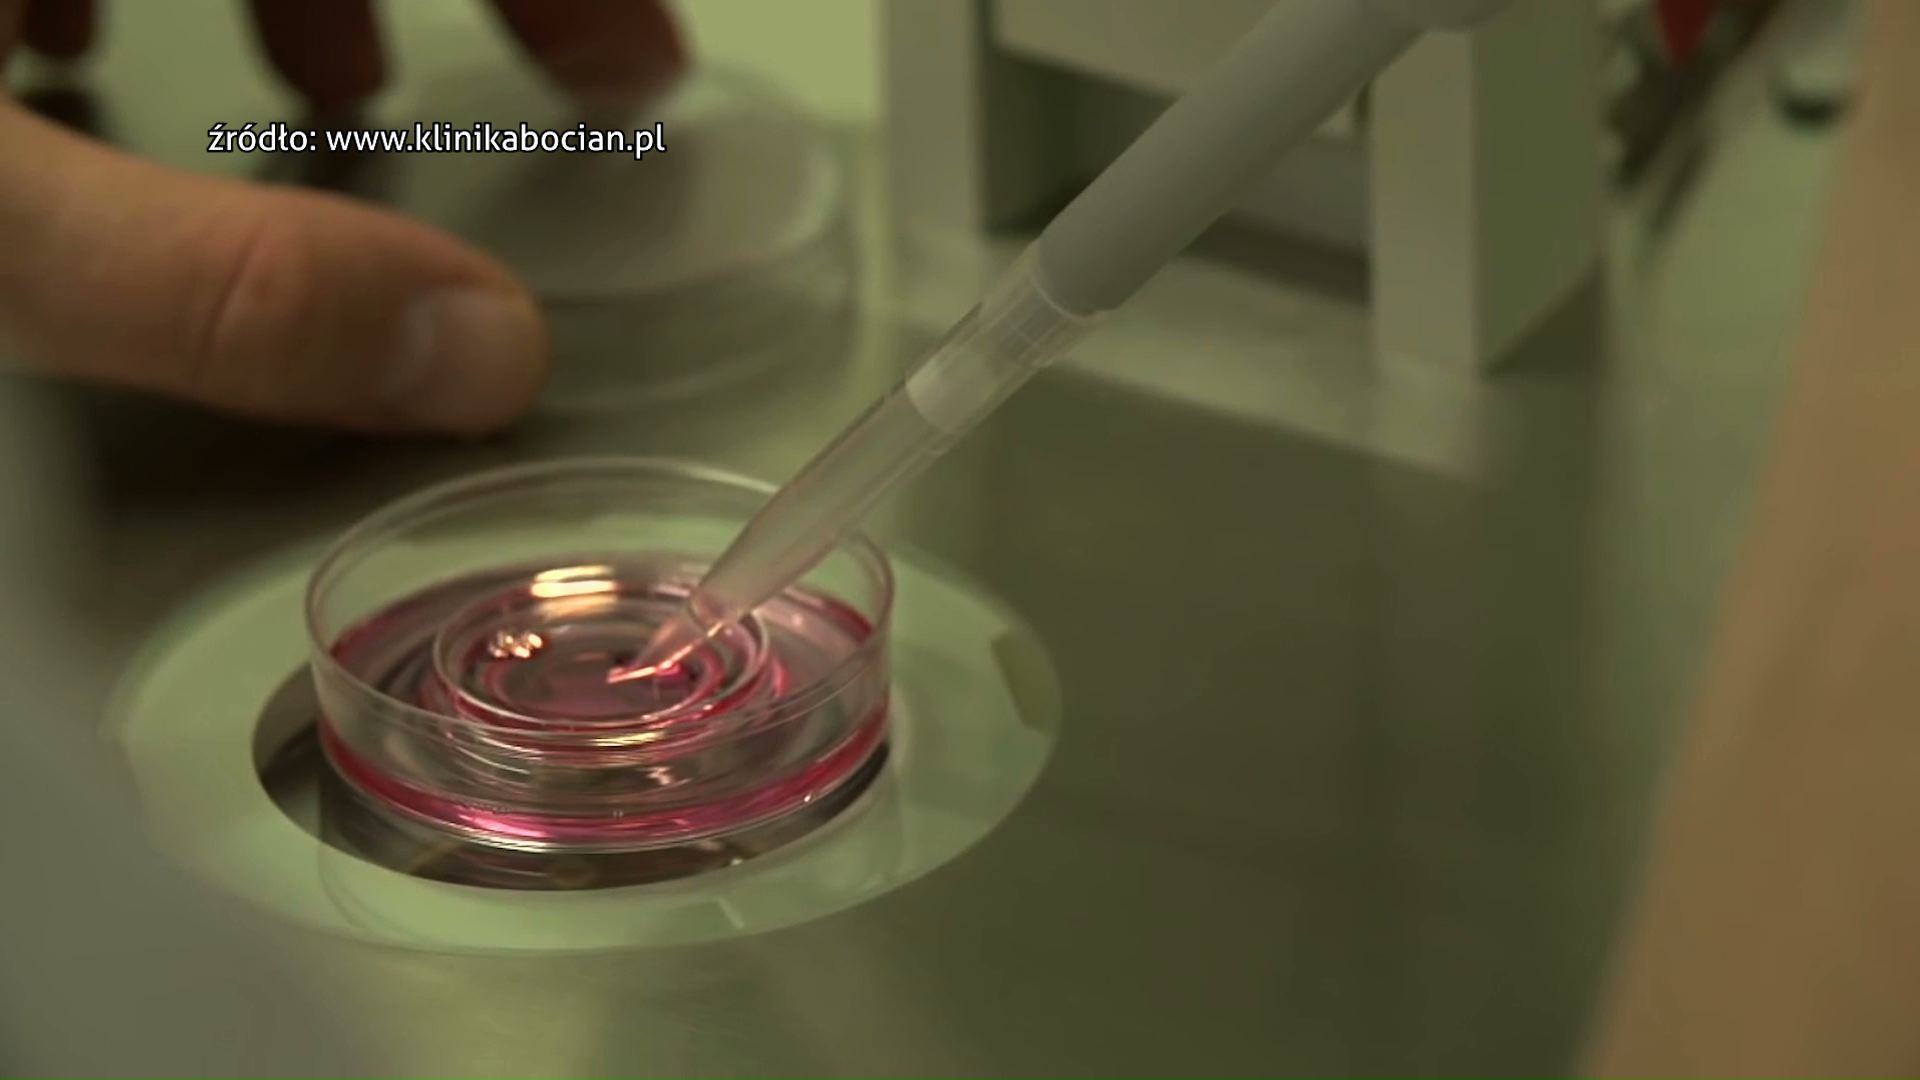
Sosnowiec podsumowuje 3 lata programu in vitro. Ma być nadal kontynuowany

Polecane
-
#News najnowsze

Kredyt na mieszkanie dla młodych – od czego zacząć i jak się przygotować?
Uzyskanie kredytu hipotecznego wymaga spełnienia kilku podstawowych warunków, z których pełnoletniość to dopiero pierwszy krok. Dla młodych osób planujących zakup…
Czytaj więcej -

-

-

-
INFORMACJE

Niezwykły koncert z Rudy Śląskiej już w niedzielę w Telewizji TVS
To okazja by zobaczyć występy artystów, którzy w listopadzie stworzyli niezwykłe wydarzenie pełne emocji, energii i wspólnej zabawy. Wyjątkowa szansa,…
Czytaj więcej -

-

-

Silesia Flesz VIDEO
-
INFORMACJE

Pierwszy śnieg. Bilans zdarzeń drogowych ostatniego weekendu
Pogoda nie jest idealna do jazdy samochodem, bo przez weekend tak jak głosiły prognozy pogody – spadło trochę śniegu. Policja…
Czytaj więcej -
INFORMACJE

Aktualizacja: Podaruj innym cząstkę siebie. Relacja z wydarzenia
Podaruj innym cząstkę siebie to wydarzenie dla tych i o tych, którzy codziennie ratują ludzkie życie. To pierwszy raz w…
Czytaj więcej -
#News najnowsze

Park Repecki w Tarnowskich Górach – nowy rezerwat przyrody w sercu Śląska
Park Repecki w Tarnowskich Górach to wyjątkowy obiekt przyrodniczy, który zostanie objęty ochroną jako rezerwat przyrody. Planowana inicjatywa jest częścią…
Czytaj więcej -
Film

Czy po obejrzeniu tego filmu wstąpiłbyś do Policji?
Policjanci z Komendy Miejskiej Policji w Rudzie Śląskiej stworzyli wyjątkowy film promujący zawód policjanta i zachęcający do wstąpienia w policyjne…
Czytaj więcej -
Dzieje się

Uroczyste ślubowanie nowych policjantów na Placu Chrobrego w Katowicach
Na Placu Chrobrego w Katowicach odbyło się pierwsze w tym roku, a zarazem największe w kraju uroczyste ślubowanie 199 nowych…
Czytaj więcej